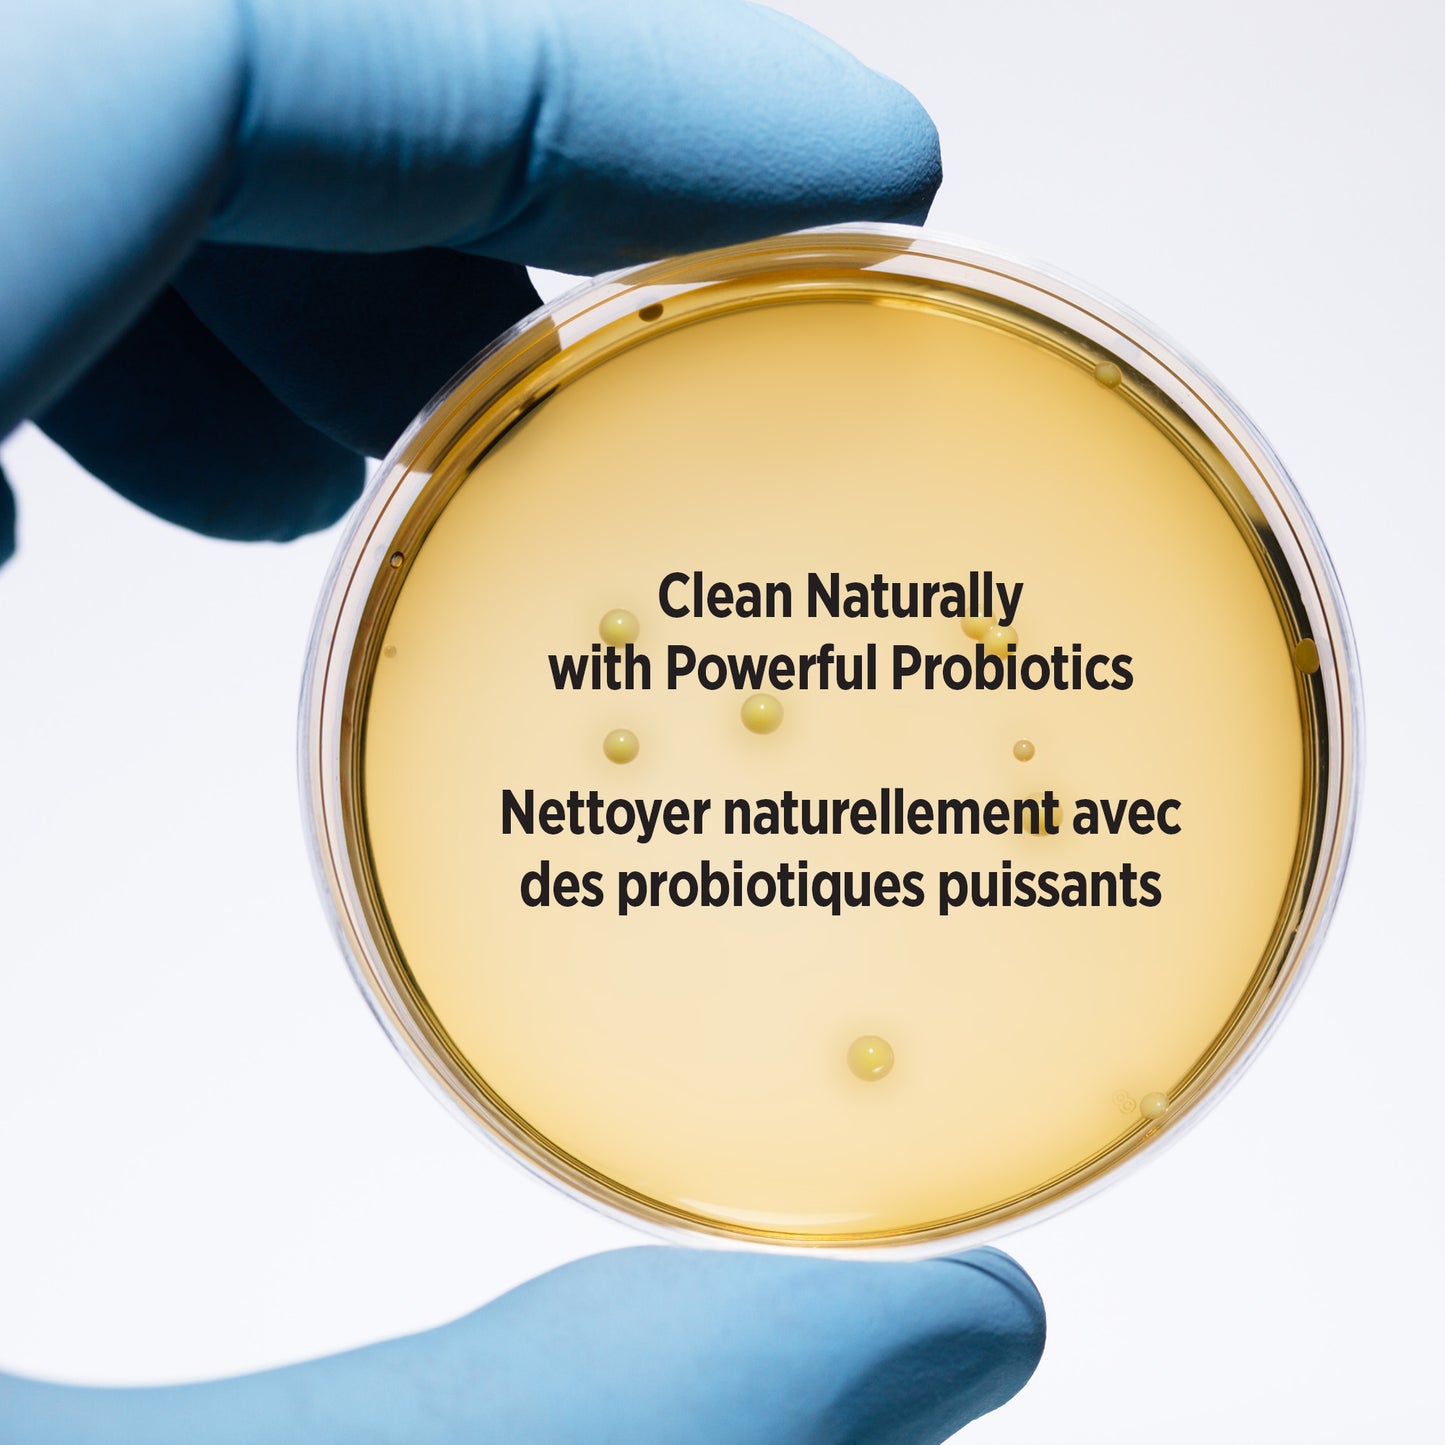

PROBIOTIC PET ODOUR & STAIN REMOVER
PROBIOTIC PET ODOUR & STAIN REMOVER
SKU:WAHL-58325
In stock
Couldn't load pickup availability
Naturally eliminates organic matter that causes stains and odour
Our probiotic formula contains live cultures that completely break down and eliminate organic waste. This long-lasting, active formula will keep working until the stain and odour is completely gone preventing repeat accidents in the same area. Safe and non-toxic for pets and home, it can be used on carpets, upholstery and hard surfaces. It can even be added to the carpet cleaning machine or as a laundry pre-wash for extra cleaning power.
Key Features
- Effectively eliminate stains and odours at their source
- Can be used as a laundry pre-wash of in the carpet cleaner machine
- Versatile multi-surface formula can be used on tiled and wood floors, carpets, fabric, and upholstered furniture
- Designed to rapidly break down and eliminate organic waste like urine, feces, blood and vomit

What’s in the Box?

- Wahl PROBIOTIC Pet Odour & Stain Remover
-
Description
 PROBIOTIC PET ODOUR & STAIN REMOVER
PROBIOTIC PET ODOUR & STAIN REMOVER
⚠️
Important Notice: Delays may occur due to carrier disruptions - Canada Post strike.
Orders placed before 11:30 AM EST ship same business day (excl. weekends/holidays).
All items ship from Markham, ON. Estimated delivery times are provided by carriers and may vary.
Pricing Table:
| Province | 0–24.99 | 24.99–49.99 | 50+ |
|---|---|---|---|
| ON (Ontario) | 5 | 4 | 0 |
| QC (Quebec) | 6 | 5 | 0 |
| BC (British Columbia) | 15 | 12 | 0 |
| AB (Alberta) | 15 | 12 | 0 |
| MB (Manitoba) | 15 | 12 | 0 |
| Province | 0–49.99 | 49.99–99.99 | 100+ |
|---|---|---|---|
| NB (New Brunswick) | |||
| NS (Nova Scotia) | |||
| PEI (Prince Edward Island) | |||
| SK (Saskatchewan) |
| Province | 0–199.99 | 200+ |
|---|---|---|
| NFL (Newfoundland & Labrador) | 30 | 0 |
| YK (Yukon) | 30 | 0 |
| NT (Northwest Territories) | ||
| NU (Nunavut) | 50 | 0 |











